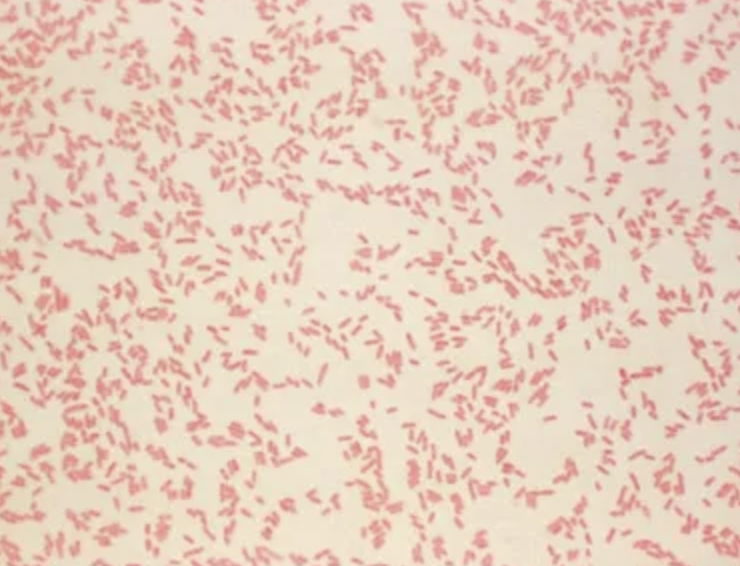

What is gastroenteritis?
How is it different from gastritis and enteritis?
Gastritis:
- inflammation of the stomach that presents with N&V
Enteritis:
- inflammation of the intestines that presents with diarrhoea
Gastroenteritis:
- inflammation of the stomach + intestines that presents with N&V + diarrhoea
What is the most common cause of gastroenteritis?
What must be done if you suspect someone has this?
- it is most commonly viral
- most patients have an affected family member / contact as it is highly contagious
- the patient must be isolated to prevent spread to others
What are the potential causes of viral gastroenteritis?
- rotavirus
- norovirus
- adenovirus
adenovirus is less common and presents with a more subacute diarrhoea
What type of E. coli is associated with gastroenteritis and how is it spread?
- E. coli is a normal intestinal bacteria
- only certain strains produce gastroenteritis (E. coli 0157)
- it is spread through contact with infected faeces, unwashed salads or water
How does E. coli 0157 produce symptoms?
What are they?
- E. coli 0157 produces the Shiga toxin
- the toxin causes abdominal cramps, bloody diarrhoea + vomiting
- the Shiga toxin destroys blood cells and leads to haemolytic uraemic syndrome (HUS)
What should be avoided if E. coli gastroenteritis is suspected?
!! antibiotics !!
- the use of antibiotics increases the risk of HUS
- antimotility medication (e.g. loperamide) can also increase the risk
this is the main reason why antibiotics / loperamide are not typically used to treat gastroenteritis
What is meant by haemolytic uraemic syndrome (HUS)?
- there is thrombosis in the small blood vessels throughout the body
- it is characterised by a triad of:
- thrombocytopenia (low platelets)
- AKI (kidneys fail to excrete waste incl. urea)
- haemolytic anaemia (due to RBC destruction)
90% of cases occur in children due to Shiga toxin-producing E.coli
Shigella can also produce the Shiga toxin
What is the presentation of HUS?
- the symptoms typically start 5 days after bloody diarrhoea due to gastroenteritis
- reduced urine output (due to AKI)
- hypertension
- haematuria (dark brown urine)
- abdo pain
- lethargy / irritability / confusion
- bruising
multiple blood clots in small vessels = thrombotic microangiopathy
What is involved in the management of HUS?
- it is a medical emergency as it has a high mortality (10%)
- management is supportive:
- antihypertensives
- blood transfusion if required to treat haemolytic anaemia
- haemodialysis if severe AKI
70-80% of patients with HUS will make a complete recovery
How is gastroenteritis caused by Campylobacter jejuni typically spread?
- also known as “travellers diarrhoea”
- raw or improperly cooked poultry
- untreated water
- unpasteurised milk
it is the most common bacterial cause of gastroenteritis worldwide
What type of bacteria is Campylobacter jejuni?
gram-negative bacteria that is curved or spiral shaped

Campylobacter - “curved bacteria”
What are the symptoms of Campylobacter jejuni gastroenteritis and how do they develop?
- there is a 2-5 day incubation period
- symptoms resolve after 3-6 days
- diarrhoea (often with blood)
- vomiting
- fever
- abdominal cramping
What is the treatment for Campylobacter jejuni gastroenteritis?
- antibiotics are considered ONLY after isolating the organism
AND
- when patients have severe symptoms or other RFs (HIV / HF)
- azithromycin or ciprofloxacin are used
How is Shigella spread?
What is the risk associated with this?
- spread through faeces contaminating drinking water, swimming pools or food
- can produce the Shiga toxin and cause HUS
What are the symptoms of Shigella gastroenteritis?
What treatment is given?
- incubation period is 1-2 days
- symptoms resolve within 1 week without treatment
- azithromycin or ciprofloxacin may be considered in severe cases
symptoms include abdominal cramps, bloody diarrhoea and fever
How is salmonella spread?
- spread through eating raw eggs / poultry
OR
- food contaminated with infected faeces of small animals
What are the symptoms of salmonella gastroenteritis?
Is treatment required?
- incubation period is 12 hours - 3 days
- symptoms resolve within 1 week
- the main symptom is watery diarrhoea that can be associated with mucus or blood
- there is also abdo pain + vomiting
antibiotics are only given in severe cases and are guided by stool culture + sensitivity
What type of bacteria is Bacillus Cereus?
How is it spread?
- it is a Gram positive rod
- it is spread through inadequately cooked food
- it grows well on food not immediately refrigerated after cooking
- typically, associated with fried rice left out at room temperature

What is the course of symptoms like when Bacillus cereus is ingested?
Why do these occur?
- it produces the toxin cereulide whilst growing on the food
- cereulide causes abdominal cramping + vomiting within 5 hours of ingestion
- when it arrives in the intestines it produces different toxins that cause a watery diarrhoea
- this occurs more than 8 hours after ingestion
- all symptoms resolve within 24 hours
typical course = vomiting after 5 hrs, diarrhoea after 8 hours and resolution within 24 hours
What other conditions are associated with Bacillus cereus?
- IVDUs can develop infective endocarditis as a result of Bacillus cereus infection
- Staphylococcus is the most common cause of infective endocarditis in IVDUs
What type of bacteria is Yersinia Enterocolitica?
How does it cause infection?
- it is a Gram-negative bacillus
- eating raw or undercooked pork causes infection
- also spread through contamination with urine / faeces of mammals such as rats or rabbits
What are the typical symptoms associated with Yersinia Enterocolitica infection?
- it typically affects children and causes:
- watery or bloody diarrhoea
- abdominal pain
- fever
- lymphadenopathy
- incubation period is 4-7 days
- the illness can last for up to 3 weeks
How is the presentation of Yersinia infection different in adults / older children?
- they may present with right-sided abdominal pain due to mesenteric lymphadenitis + fever
- this can give the impression of appendicitis
mesenteric lymphadenitis = inflammation in the intestinal lymph nodes
What is the treatment for Yersinia infection?
- antibiotics are only given in severe cases
- they are guided by stool culture + sensitivities




